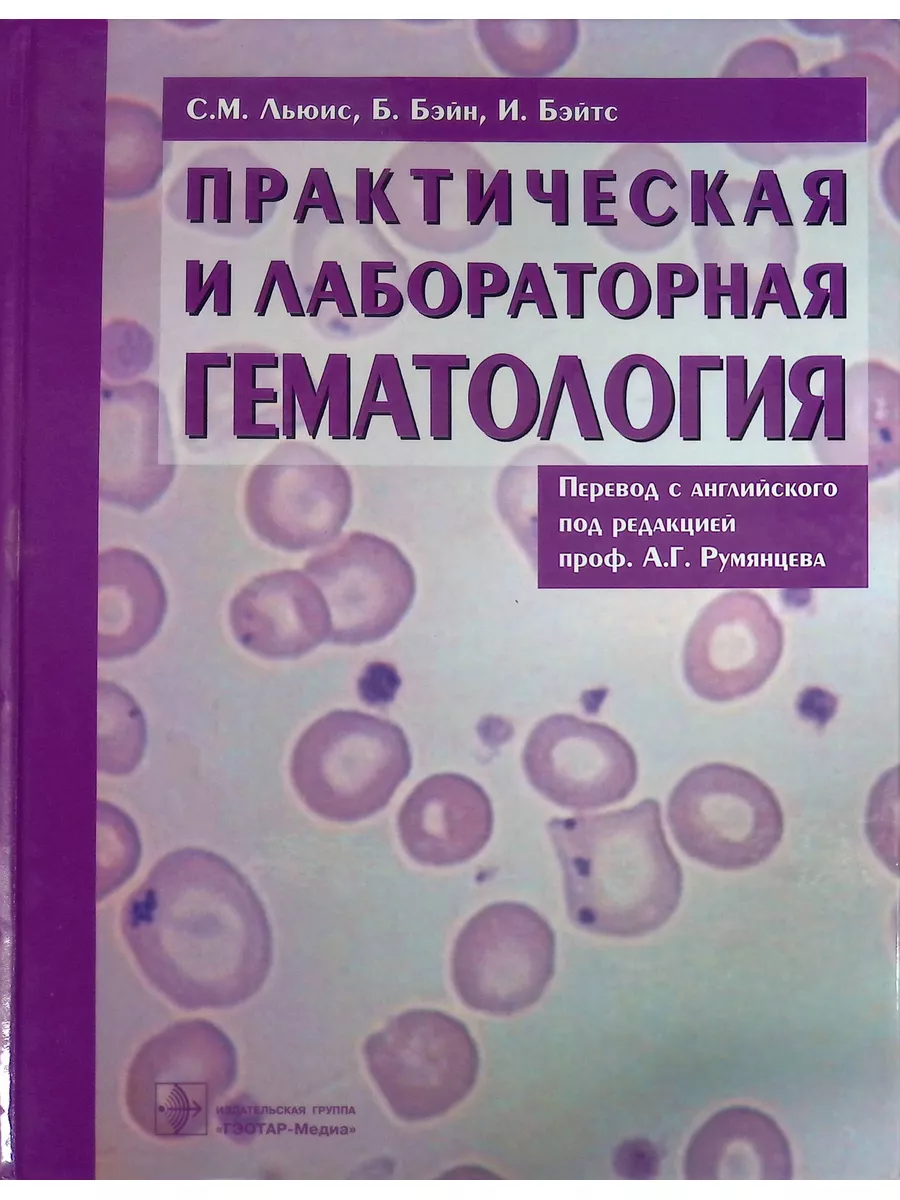

кая атласы
Луговская атласы 160 фото
Почему болтается ступица
Clt 1
Беродуал ингаляции при лающем кашле
Genius netscroll 110
Сетевое значение частоты
Погода ульяновск 21
352 котлас расписание
Недорогие телефоны самсунг все модели
Vue validate
Колит левое ребро с боку